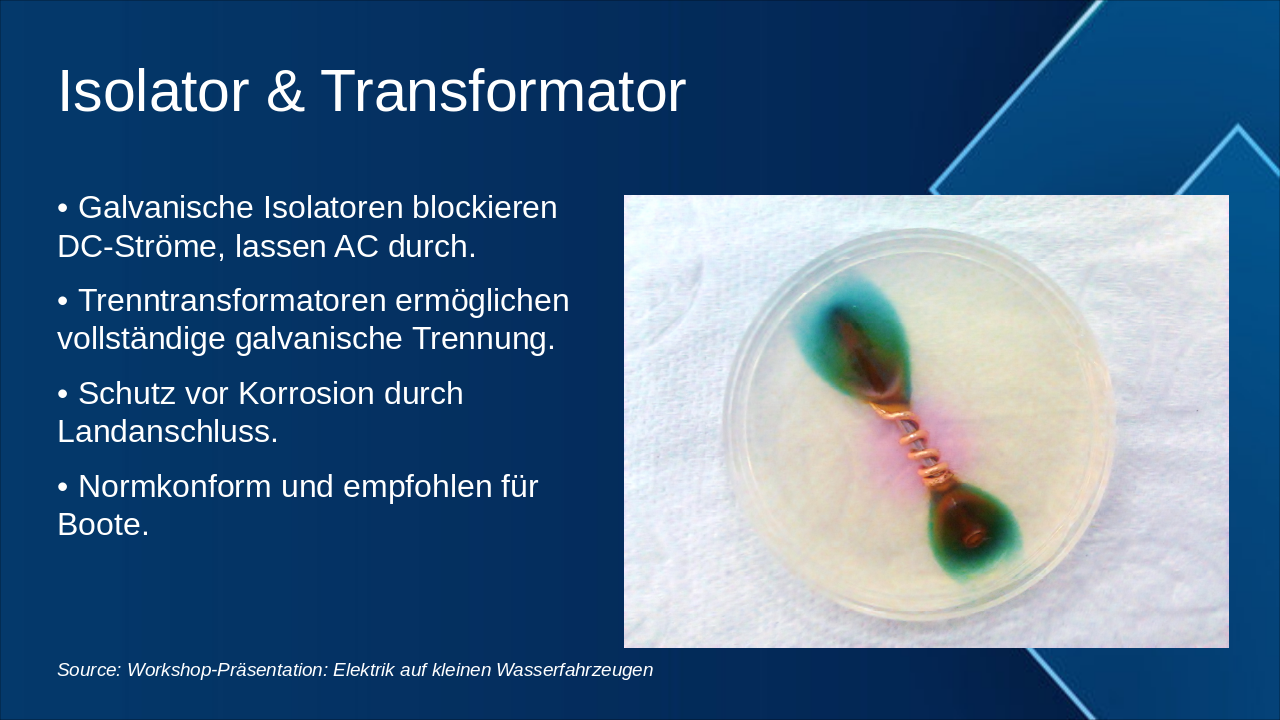

Slide 1 - Elektrik auf kleinen Wasserfahrzeugen
This title slide is titled "Elektrik auf kleinen Wasserfahrzeugen," meaning "Electrics on Small Watercraft." The subtitle outlines "Grundlagen, Normen und praktische Hinweise für den Workshop," covering basics, standards, and practical workshop tips.
Elektrik auf kleinen Wasserfahrzeugen
Grundlagen, Normen und praktische Hinweise für den Workshop
Source: Workshop-Präsentation: 'Elektrik auf kleinen Wasserfahrzeugen'